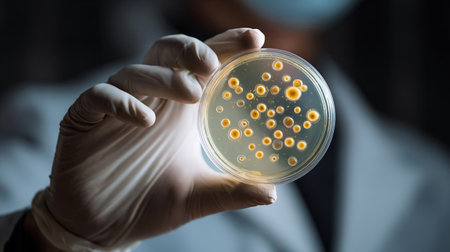
Science and Life. A scientist holding a Petri Dish with Virus and bacteria cellsの素材

素材 - Science and Life. A scientist holding a Petri Dish with Virus and bacteria cells
作品情報
Science and Life. A scientist holding a Petri Dish with Virus and bacteria cells
- ID:254113734
- 作品種別:
- 作者名:Volodymyr Shcherbak
キーワード
- agents
- analysis
- asian
- bacteria
- biochemistry
- biology
- blood
- blood test
- blue
- care
- cells
- concept
- conditions
- controlled
- dish
- drugs
- effects
- equipment
- experiments
- facility
- flare
- flu
- gloves
- green
- growth
- hand
- health
- holding
- hygiene
- infectious
- lab
- laboratory
- life
- lifestyle
- lights
- measure
- petri
- public
- research
- results
- safety
- science
- scientific
- scientist
- special
- technology
- vaccine
- virus
- wear
- white
類似作品
selective focus...
Doctor holding ...
Young woman sci...
Doctor holding ...
A laboratorian ...
A man is holdin...
A researcher in...
Futuristic medi...
AI-powered glob...
Woman in white ...
Medicine of the...
Female doctor h...
Laboratory glas...
Doctor holding ...
Expert Medical ...
Science laborat...
close up.a focu...
Scientist exami...
Digital medicin...
Doctor holds in...
Scientist holdi...
glass ball in t...
Scientist worki...
Doctor with syr...
science, biolog...
Scientist in a ...
The Revolutiona...
Young woman mix...
scientist worki...
lab, team of me...
A scientist in ...
Doctor in blue ...
Little scientis...
Female scientis...
Female doctor w...
Chemist working...
Nurse in mask a...
Scientist worki...
Medical care in...
Man, scientist ...
A scientist wea...
science, chemis...
woman examining...
scientist worki...
Man hold human ...
Food Quality As...
AI generated im...
Dedicated scien...